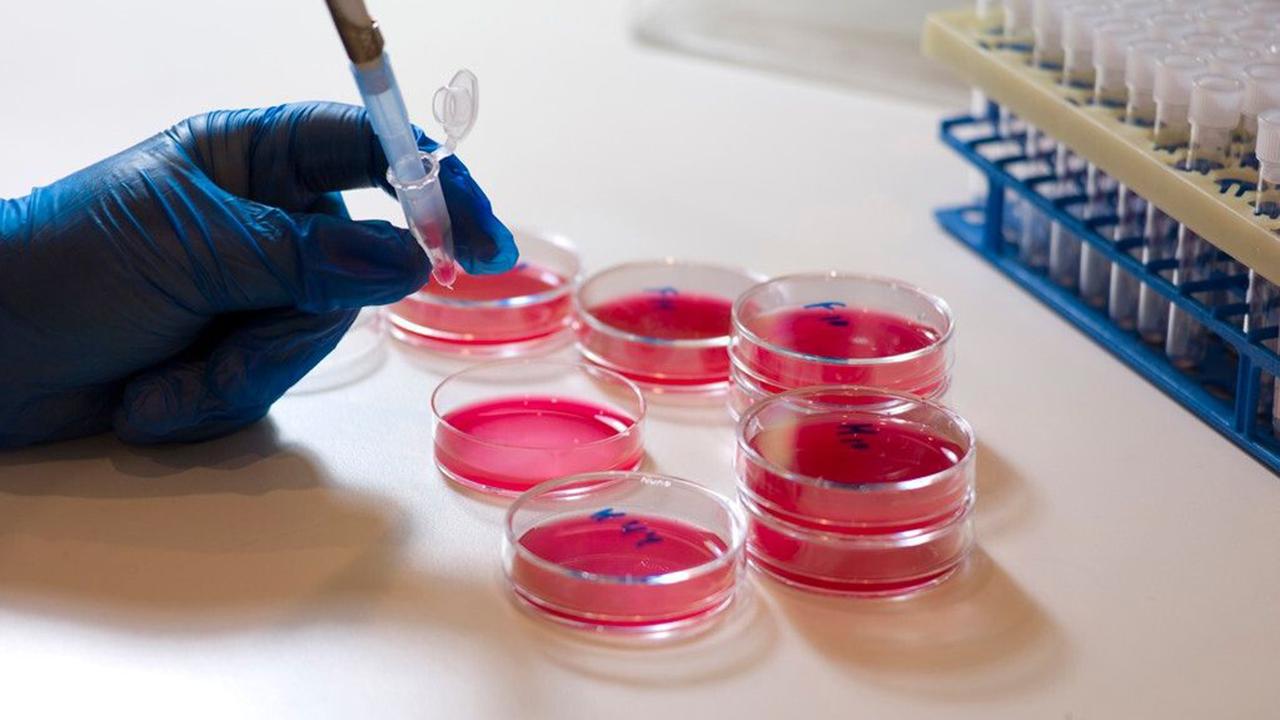
辟谣丨抗生素就是消炎药吗？两大常用抗生素，很多人都用错了

“咳咳咳……”小张已经咳嗽好几天了,她本来以为两三天就会好,就一直没有去医院,结果症状越来越重。

妈妈知道以后立即从家里翻出药箱,拿出了头孢和阿莫西林,对着女儿说道:“你这就是感冒了,吃几天消炎药就好了,我以前都是这样的。”
像小张妈妈这样的人其实不在少数,很多人都认为抗生素就是消炎药,咳嗽、发烧或者是喉咙疼都可以吃。
但事实并非如此,抗生素并不等于消炎药,也不能随意服用。下面我们就一起来了解一下抗生素和消炎药的相关知识。
抗生素就是消炎药吗?什么是消炎药?
消炎药即消除或抑制炎症的药物。抗生素是从微生物或者高等植物活动过程中提取出来的一种物质,能够干扰部分细胞的发育,比如细菌、支原体等。抗生素主要是针对病原体感染,通过阻止病原体繁殖达到抑制炎症的效果。

但炎症并不一定都是病原体感染引起的,免疫系统的疾病、组织坏死、高温烫伤等因素都有可能引起炎症,所以抗生素不能算作是真正意义上的消炎药。
从专业角度来讲,消炎药主要是指类固醇类消炎药和非类固醇类消炎药。其中,类固醇类消炎药就是我们通常说的激素,包括地塞米松、氢化可的松、泼尼松等。激素类药物可以在较短的时间内改善毛细血管通透性,减少渗出,从而减轻炎症反应。

但类固醇类消炎药的副作用较多,比如肥胖、内分泌失调、骨质疏松等。不宜长期、大量应用,需要有专业人士指导。
非类固醇类消炎药包括吲哚美辛、阿司匹林、对乙酰氨基酚等,能够缓解炎症引起的疼痛、肿胀,还有一定的退热功效。
常用的两大抗生素
青霉素类药物
常见的青霉素类药物包括青霉素G、阿莫西林、哌拉西林等,是比较早出现的一种抗生素,能够抑制部分细菌的细胞壁合成,从而达到杀菌、抑菌的效果。青霉素的抗菌谱相对较窄,主要针对葡萄球菌、炭疽杆菌、破伤风梭菌等革兰阳性菌感染。

临床上经常会用青霉素类药物治疗梅毒、猩红热、丹毒、蜂窝织炎等疾病,有较为理想的治疗效果。
因为人体细胞中不含有细胞壁,所以青霉素类药物对机体的影响较小,属于比较安全的药物。部分人群用药后可能会出现药疹、过敏等不良反应,停止用药后会逐渐缓解。

头孢菌素类药物
头孢呋辛、头孢克肟、头孢哌酮等都是较为常见的头孢菌素类药物,和青霉素类药物同属于β-内酰胺类抗菌药物。相比于青霉素类药物,头孢菌素的抗菌谱更广,副作用也相对较轻,在临床应用更加广泛。
头孢菌素目前已经研究至*四代第**,对革兰阳性菌和革兰阴性菌都有较为理想的抑制作用,安全性也更为优越。
除了以上两种药物,大环内酯类抗生素、喹诺酮类药物也是常见的抗生素。
抗生素使用的常见误区
抗生素被过度使用。头孢、青霉素类药物在家庭的应用十分广泛,甚至被当做常备药。很多人在出现腹泻、咳嗽等疑似感染的症状后就会自行服用抗生素,*疮痤**、毛囊炎等较轻的细菌感染也会应用抗生素治疗。
人体具有抵御外界病原体入侵的能力。当细菌、病毒等病原体进入人体后,机体的免疫系统会产生相应的免疫反应,清除抗原。较轻的炎症感染大多可以自愈,并不需要过早应用抗生素治疗。

抗生素等级越高越好。很多人认为抗生素等级越高,治疗效果越好,甚至直接要求使用二级、三级的抗生素。
虽然高级抗生素的抗菌效果更好,但临床主张循序渐进地用药,如果炎症感染并不严重,使用一级抗生素也能起到预期的治疗效果。过早应用高等级抗生素,容易引起耐药菌感染。
抗生素的正确使用方法
明确炎症类型。在出现炎症症状后,可以做血常规、分泌物培养等检查,明确病因。如果确实存在某种细菌感染,且病情较为严重,可以再做药敏试验,进而选择敏感的抗生素药物进行治疗,不要随意使用广谱类抗生素。
如果是病毒感染或者是不明原因的炎症,不建议一开始就应用抗生素。
遵医嘱用药。很多人在发现自己有感染症状后,会随意服用抗生素药物,而且不注重剂量和服用的时间,这样很难起到预期的治疗效果,也会加重抗生素滥用的情况。
大家应在医生的指导下按疗程使用抗生素,不宜自行停药、增加或减少药物的剂量。
用药前完善过敏试验。青霉素类药物和头孢类药物有可能会引起比较严重的过敏反应,甚至会出现休克的情况,所以在肌肉注射或者是静脉用药前,应做好皮试。如果皮试发现对该药物过敏,则需要在医生的指导下更换其他类型的药物。

用药期间的注意事项。很多抗生素药物会引起一些不良反应,如呕吐、食欲不振、皮肤瘙痒等。所以在用药期间,我们需要调整饮食,以清淡、易消化为主,不宜食用辛辣、油腻的食物。应用头孢类药物的人群严禁喝酒,避免出现双硫仑反应,危及生命。
滥用抗生素的坏处
国外对于抗生素药物有非常严格的管控,我国也在逐渐加大对抗生素的监管力度,这是因为滥用抗生素会产生较多的危害:
首先是毒副作用。部分抗生素具有肾毒性、肝毒性、耳毒性,如果只是偶尔应用,一般不会对身体产生太大的危害。但如果长期应用某种抗生素,就有可能导致脏器或神经损伤,引起耳聋、肾病等问题。

其次是产生耐药性。细菌、寄生虫等病原体会根据环境变化而做出相应的改变,早期应用抗生素药物治疗时,效果大多较为理想。但如果长期应用某种抗生素,体内病原体的耐药性便会不断提高,药物治疗效果会越来越差,需要不断更换新的抗生素。
部分人群最后甚至会出现多重耐药菌感染,而目前针对这种情况尚没有理想的治疗方法。
另外,滥用抗生素还有可能危害肠道的健康。抗生素对肠道内菌群的影响较大,有可能引起腹泻、腹痛等不适,还会阻碍肠道黏膜对营养物质的吸收,长期如此容易造成营养不良。同时也会对自身抵抗力产生不利影响。

如何避免滥用抗生素
- 对疾病有正确的认知
上呼吸道感染是比较常见的感染性疾病,很多人在出现咳嗽、咳痰、头痛等感症状后就会自行服用抗生素药物。但大部分上呼吸道感染都是由病毒感染引起,单纯服用抗生素药物没有很明显的治疗效果,还会增加病原体的耐药性。所以正确认识疾病、及时就医很有必要。
- 尝试中医疗法
中医疗法是一种传统的治疗方法。以感冒为例,蒲公英、金银花、柴胡、防风等中药有一定的疗效,而且和抗生素相比,毒副作用较小,也不会产生耐药性。不过服用中药一定要有专业医师指导,不能自行配伍用药,也不能随意增减药物剂量。

- 增强自身抵抗力
部分人身体抵抗力较差,比健康人群更加容易患病,且病后无法快速自愈,就会更加依赖于见效快的抗生素药物。因此,提高自身抵抗力很有必要。
身体抵抗力较差的人群需要养成良好的作息习惯,保证充足的睡眠时间,不宜熬夜。同时还应注意营养均衡,适当增加优质蛋白质以及铁、锌、钙等微量元素的摄入,也可以多吃新鲜的水果,补充维生素C。

- 避免单一用药
如果确实存在较为严重的细菌感染,需要长期应用抗生素药物,应在医生的指导下定期轮换使用,可以提高治疗效果。如果长期应用单一抗生素,不仅治疗效果会越来越差,也会更容易产生抗药性。
写在最后
我国滥用抗生素的情况十分严重,很多人因为感染耐药菌而无法得到有效治疗。如果把抗生素当做消炎药使用,则会继续加重这一现象。因此,规范使用抗生素尤为重要。
希望大家在出现身体不适后能够及时就医,在专业医师的指导下进行规范化的治疗,而不是自己随意服用药物。
参考文献:
【1】冀连梅《你还在把抗生素叫成消炎药吗?》
【2】汪复《抗菌药物临床应用指南》